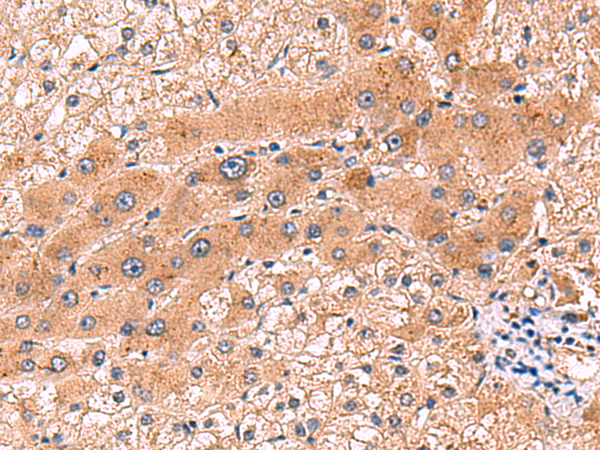

中文名稱:兔抗CCL13多克隆抗體
英文名稱: Anti-CCL13 rabbit polyclonal antibody
別 名: NCC1, CKb10, MCP-4, NCC-1, SCYL1, SCYA13
抗 原: CCL13
儲 存: 冷凍(-20℃)
相關(guān)類別: 一抗
技術(shù)規(guī)格
|
Background: |
This antimicrobial gene is one of several Cys-Cys (CC) cytokine genes clustered on the q-arm of chromosome 17. Cytokines are a family of secreted proteins involved in immunoregulatory and inflammatory processes. The CC cytokines are proteins characterized by two adjacent cysteines. The cytokine encoded by this gene displays chemotactic activity for monocytes, lymphocytes, basophils and eosinophils, but not neutrophils. This chemokine plays a role in accumulation of leukocytes during inflammation. It may also be involved in the recruitment of monocytes into the arterial wall during artherosclerosis. |
|
Applications: |
ELISA, WB, IHC |
|
Name of antibody: |
CCL13 |
|
Immunogen: |
Fusion protein of human CCL13 |
|
Full name: |
C-C motif chemokine ligand 13 |
|
Synonyms: |
NCC1; CKb10; MCP-4; NCC-1; SCYL1; SCYA13 |
|
SwissProt: |
Q99616 |
|
ELISA Recommended dilution: |
5000-10000 |
|
IHC positive control: |
Human liver cancer |
|
IHC Recommend dilution: |
80-400 |
|
WB Predicted band size: |
11 kDa |
|
WB Positive control: |
Human ileum tissue lysate |
|
WB Recommended dilution: |
500-2000 |

購物車
幫助
021-54845833/15800441009
